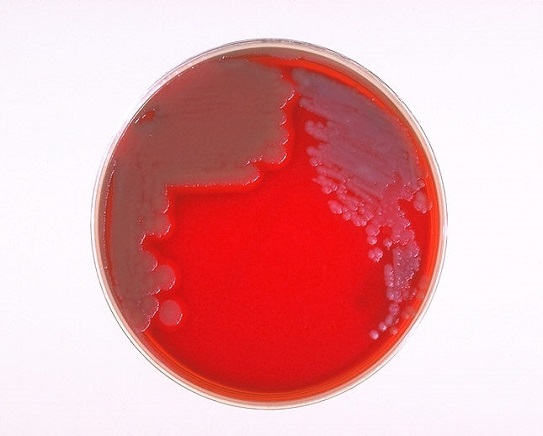

Sheep Blood Agar Plate
For the non-selective cultivation of microorganisms. General growth media for bacteria, yeast, and fungi Contains 5% sheep blood from a veterinary supervised, controlled herd of donor animals. Blood is guaranteed to be from healthy antibiotic-free animals Polystyrene Petri plates feature raised rings for stacking ability and prevents sliding Packaged in sleeves of 10 plates in a "breathable" bag that prevents build-up of condensation and excess moisture The Hardy Diagnostics manufacturing facility and quality management system comply with cGMP's and have achieved ISO 13485 certification as a medical device manufacturer This product is for human diagnostic use
